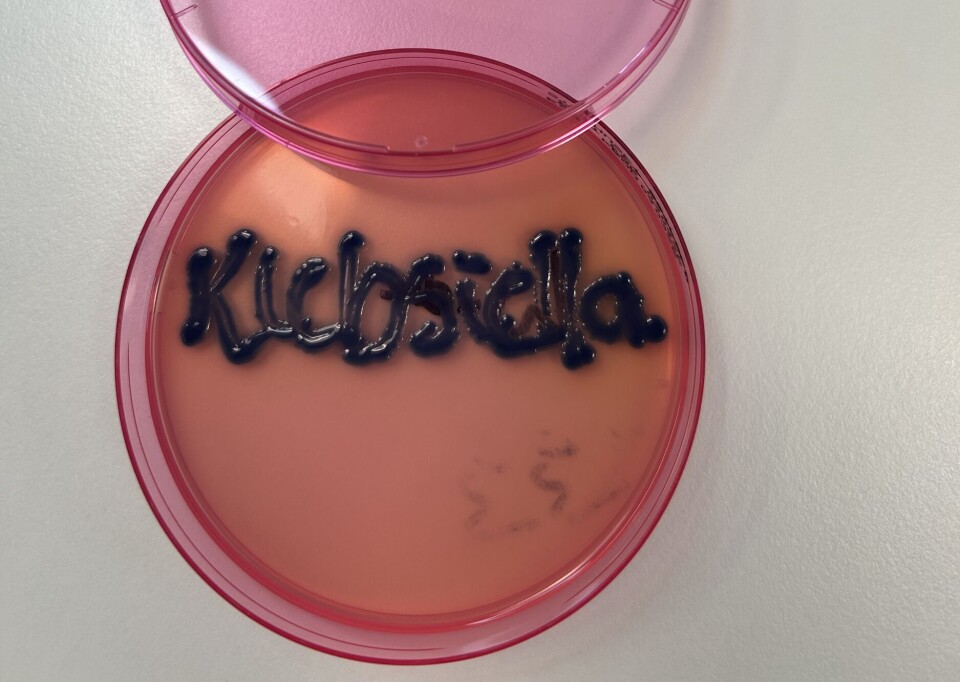

Fra fagmiljøene
Toaletter og avløpssystem - reservoar for polyklonale utbrudd med resistente mikrober
Kartlegging av smitteutbrudd ble iverksatt etter at bioingeniører reagerte på økt forekomst av ESBL-produserende bakterier. Analysering av toalettvann og sluk avdekket at avløpssystemet trolig var reservoar for et langvarig utbrudd.
Last ned pdf
Studien er et samarbeidsprosjekt mellom Avdeling for smittevern ved Sykehuset Østfold, Senter for laboratoriemedisin ved Sykehuset Østfold, Nasjonalt senter for påvisning av antibiotikaresistens (K-res), Universitetssykehuset i Nord-Norge og UiT Norges arktiske universitet. Artikkelen er publisert i tidsskriftet «Infection Prevention in Practice» i desember 2024.
- Sykehuset Østfold, Avdeling for smittevern
- Sykehuset Østfold, Senter for laboratoriemedisin, Seksjon bakteriologi
- Universitetssykehuset Nord-Norge, Nasjonalt senter for påvisning av antibiotikaresistens (K-Res)
Utover høsten 2021 la bioingeniører ved Seksjon for bakteriologi ved Sykehuset Østfold merke til en økning i funn av Klebsiella oxytoca-isolater som var ekstendert spektrum betalaktamase (ESBL)-produserende. Produksjon av betalaktamaser med utvidet spektrum gir resistens mot mange hyppig brukte antibiotika, inkludert penicilliner og cefalosporiner. Disse isolatene ble først og fremst funnet i urinprøver, men ble også påvist stadig hyppigere fra blodkulturer. Andelen av K. oxytoca blodkulturisolater med ESBL var gradvis økende fra 2016 og nådde 37 % i 2021. Et utbrudd ble mistenkt, og smittevernavdelingen ble varslet.
Smittevern opplevde situasjonen som alvorlig, og det ble utført en grundig kartlegging hvor de fant at de fleste pasientene (75 %) hadde vært inneliggende på samme avdeling, men ikke på samme tid. Statistikk fra laboratoriedatasystemet tydet også på at utbruddet hadde pågått over tid. På bakgrunn av dette oppsto mistanken om at en miljøkilde var reservoar for utbruddet, og smittevern startet jakten på smittekilden.
K. oxytoca assosieres ofte med vandige miljøer, og et litteratursøk avslørte at det er beskrevet flere utbrudd i sykehus der kilden har vært sluk i vask (1-4). Denne informasjonen, sammen med erfaringer fra et annet nylig utbrudd ved samme sykehus, medførte prøvetaking fra vask, dusjsluk og vann i toalettskåla. Hypotesen var at biofilmdannelse i avløpssystemet utgjorde et mangfoldig og persisterende reservoar av bakterier som medførte smitterisiko for pasientene.
Beskrivelse av arbeidet med dette smitteutbruddet resulterte i en artikkel publisert i tidsskriftet «Infection Prevention in Practice» i desember 2024 (5), og her vil vi presentere undersøkelser og funn fra utbruddsoppklaringen.
Dyrkning av miljøprøver

Toalettvannprøver ble samlet inn ved bruk av en 20-mL-sprøyte, overført til sterile beholdere og sentrifugert bunnfall ble dyrket. Prøver fra dusjavløp ble samlet inn under vannlåsen på grunn av nærheten til avløpsrørene. I utbruddsavdelingen ble vaskavløp og kraner i alle pasientrom prøvetatt. Prøver fra dusjavløp, vaskavløp og kraner ble samlet inn ved bruk av Eswab.
Prøvene fra miljøet ble dyrket på selektive medier (CHROMagar ESBL og SuperCARBA). MALDI-TOF ble brukt for artsidentifikasjon, og fenotypisk ESBL-produksjon ble bekreftet med klavulanat-synergi.
Mikrobuljongfortynning ble brukt for følsomhetstesting mot et bredt utvalg av antibiotika.
Utbruddsbakteriene ble påvist i utstrakt grad i miljøprøver fra toalettene. Undersøkelser utført på utbruddsavdelingen viste at hele 81 % (21/26) av prøvene fra toalettvannet var positive for utbruddsstammene, mens det samme gjaldt for 19 % (5/26) av prøvene fra sluk i vask og 8 % (2/26) av prøvene fra dusjsluk.
Helgenomsekvensering ga svar
I samarbeid med Nasjonalt senter for påvisning av antibiotikaresistens (K-res) ved Universitetssykehuset Nord-Norge ble det utført helgenomsekvensering av til sammen 21 isolater fra pasienter og 9 isolater fra miljøet. På utvalgte isolater ble det også utført plasmidanalyser. Helgenomsekvensering ble utført med både Illumina-teknologi (korte DNA-fragmenter) og Oxford Nanopore-teknologi (lange DNA-fragmenter), for å studere plasmider og spesifikk lokalisasjon til ESBL-genet i bakteriene.

Sekvensering avslørte at det som vi trodde var ett enkelt utbrudd, i realiteten dreide seg om en polyklonal populasjon bestående av fire ulike klynger med genetisk nært beslektede isolater. Alle isolatene fra miljøet fordelte seg i klyngene sammen med de kliniske isolatene. Resultatene fra sekvensering viste også at to av klyngene ikke besto av K. oxytoca, men Klebsiella michiganensis som også tilhører K. oxytoca-specieskomplekset. MALDI-TOF, som er standardmetoden for genus- og speciesbestemmelse, skiller foreløpig ikke mellom disse.
Isolatene fra ulike klynger viste noe ulike resistensprofiler, men felles for alle var at de hadde ESBL-genet blaCTX-M-15 eller blaCTX-M-154. Det er kun én aminosyre forskjell mellom disse variantene, som kan tyde på at genet har endret seg lokalt. Særlig interessant var funn av plasmider med høy grad av sekvenslikhet hos bakterier fra forskjellige klynger og arter. Dette tyder på horisontal genoverføring, altså overføring av plasmider mellom arter og kloner, sannsynligvis i miljøet eller i pasientene. Det ble også funnet holdepunkt for at visse genetiske elementer (insersjonssekvenser – IS-elementer), medvirket til forflytting av resistensgener innad i isolatene, da ESBL-genet ble hos noen isolater påvist i forskjellige genetiske lokalisasjoner inkludert i kromosomet.
Kontaminering i avløpssystemet over lengre tid

Miljøprøvene avslørte altså omfattende kontaminering med utbruddsstammene i avløpssystemet på den berørte sengeposten, og plasmidanalyser indikerte mulig overføring av plasmider mellom arter og kloner. Resultatene støttet hypotesen om et felles opphav for isolatene.
Alle klyngene inneholdt isolater som var påvist med mange måneders mellomrom, og i den ene klyngen var det mer enn tre år fra første kjente kliniske isolat til miljøprøven som ble tatt i juni 2022. Dette indikerer et langvarig utbrudd, og et persisterende reservoar i miljøet.
Forsterket renhold og desinfeksjon
Basert på resultatene fra miljøprøvene ble det innført forsterket renhold på de mest utsatte avdelingene. Desinfeksjon av toaletter, vasker og dusjsluk ble utført to ganger om dagen gjennom store deler av 2022. Etter å ha prøvd ut ulike regimer for desinfeksjon ble vask med Perasafe og deponering av 50 mg Rely+On Virkon valgt som rutinemetode. Innføring av målrettede renholdstiltak hadde en umiddelbar effekt på andelen blodkulturisolater med ESBL-produserende K. oxytoca (Figur 1).

Molekylære metoder er viktig ved utbruddsoppklaring
Omfattende molekylærbiologiske undersøkelser er viktig for å forstå dynamikken i komplekse utbrudd. Kombinasjonen av tradisjonell smitteoppsporing og avanserte genomiske analyser gir dypere innsikt i hvordan antimikrobiell resistens kan spre seg i sykehusmiljøer, selv når direkte pasient-til-pasient-smitte ikke er åpenbar. Den genetiske fleksibiliteten hos bakterier og spredningen av mobile genetiske elementer som plasmider med resistensgener gjør at man ikke kan utelukke at flere arter og kloner kan være involvert i et utbrudd. Dette er viktig å vurdere i utbruddsoppklaring og i hvilke sekvenseringsteknologier som benyttes.
Oppsummering
Artikkelen i «Infection Prevention in Practice» beskriver dynamikken i et sykehusutbrudd med multiresistente stammer tilhørende K. oxytoca-komplekset, påvist i urinprøver og blodkulturer. De utførte undersøkelsene dokumenterer utbredelsen av utbruddsstammene i toalettvannet på de affiserte sengepostene, og slektskap mellom isolater fra pasienter og miljøet. Resultatene viser persistens av resistente mikroorganismer i avløpet og at bakteriene trolig har evne til å migrere fra rørene til toalettskål.
Denne studien fremhever at det er viktig å vurdere toaletter og avløpssystemer som potensielle reservoarer ved utbrudd av multiresistente bakterier på sykehus. Biofilmdannelse i disse miljøene kan skape langvarige kilder til kontaminering som er vanskelige å eliminere med standard rengjøringsrutiner. Forbedret renhold på pasientbad og desinfeksjon av toaletter og avløp kan være avgjørende tiltak for å bryte smittekjeden ved slike utbrudd.
I tillegg understreker funnene viktigheten av systematisk prøvetaking fra miljøet ved utbrudd, særlig ved utbrudd som pågår over tid og der epidemiologiske funn indikerer et reservoar i miljøet. Å avdekke kilden til utbruddet er avgjørende for å iverksette riktige tiltak.
Om forfatterne
Astri Lervik Larsen: Overlege og avdelingssjef, Avdeling for smittevern, Sykehuset Østfold
Linda Frimand: Bioingeniør, Seksjon bakteriologi, Senter for laboratoriemedisin, Sykehuset Østfold
Ole Fredrik Hansen: Smittevernsykepleier, Avdeling for smittevern, Sykehuset Østfold
Ørjan Samuelsen: Professor og forsker ved Nasjonalt senter for påvisning av antibiotikaresistens ved Universitetssykehuset Nord-Norge




























